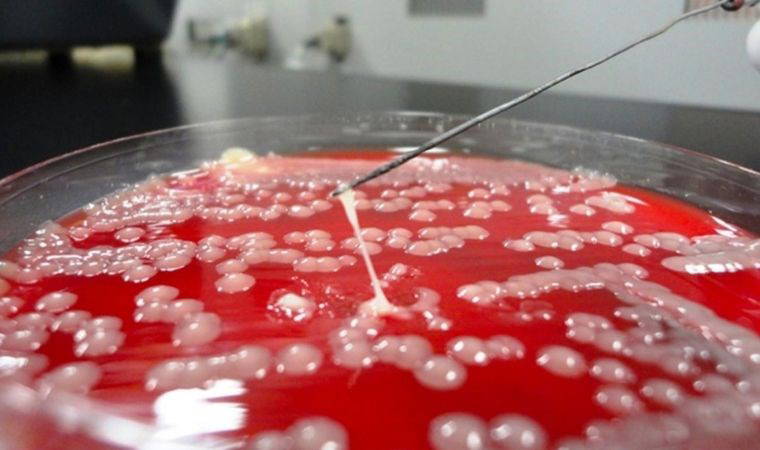

Dünya Sağlık Örgütü (DSÖ), Klebsiella pneumoniae'nin "hipervirülan" bir süper bakteri türü hakkında alarm veriyor. Kurum, mevcut antibiyotiklere karşı direnç gösteren ve herkesi ciddi şekilde hasta edebilen bu bakterinin izlenmesi için ülkeleri harekete geçmeye çağırıyor.
KLEBSIELLA PNEUMONIAE TEHLİKESİ
K. pneumoniae, toprakta ve insan mikrobiotasının bir parçası olarak yaygın bir bakteridir. Genellikle zararsız olsa da, akciğerler gibi vücudun hassas bölgelerine bulaştığında hastalığa yol açabilir. Özellikle bağışıklık sistemi zayıf olan kişilerde ciddi enfeksiyonlar oluşturabilen bu bakteri, zamanla yaygın antibiyotiklere karşı direnç kazanmıştır.
Son yıllarda doktorlar, sadece son çare olarak kullanılan karbapenem antibiyotiklerine karşı dirençli değil, aynı zamanda sağlıklı insanlarda da ciddi enfeksiyonlara neden olabilen K. pneumoniae türleriyle karşılaşmaktadır. Bu türler, hipervirülan K. pneumoniae sekans tipi 23 (hvKp ST23) olarak adlandırılmıştır.
Bu hafta, WHO bu durum hakkında önemli bir güncelleme yaptı. Kurum, artan vakalar ışığında, Global Antimikrobiyal Direnç ve İzleme Sistemi aracılığıyla dünya genelindeki ülkelere hvKp ST23 vakalarını bildirmeleri çağrısında bulundu. Yanıt veren 43 ülkeden 16'sı hvKp vakaları, 12'si ise özellikle hvKp ST23 vakaları bildirdi. Ancak, WHO bu vakaların sadece buzdağının görünen kısmı olduğunu belirtti.

TEŞHİS KONULAMIYOR
Global olarak, hvKp türlerinin rutin tanımlanması ve bilgi toplama için sistematik bir izleme mevcut değil," diyen WHO, laboratuvar kapasitesinin sınırlı olmasının bu durumun başlıca nedeni olduğunu belirtti. WHO, bu bakterilerin doğru bir şekilde tespit edilmesi için laboratuvarların genomik sekanslama testleri veya spesifik markör analizleri yapabilmesi gerektiğini vurguladı.
WHO, hvKp ST23'ün orta düzeyde bir risk taşıdığını kabul ederken, sorunun ne kadar büyük olduğunu ve gelecekte nasıl bir tehdit oluşturabileceğini anlamak için daha fazla veriye ihtiyaç olduğunu belirtti. Bu nedenle, WHO ülkeleri hvKp türlerinin izlenmesini artırmaya ve bu konuda klinisyenleri, laboratuvarları ve halk sağlığı sistemlerini bilgilendirmeye çağırıyor.